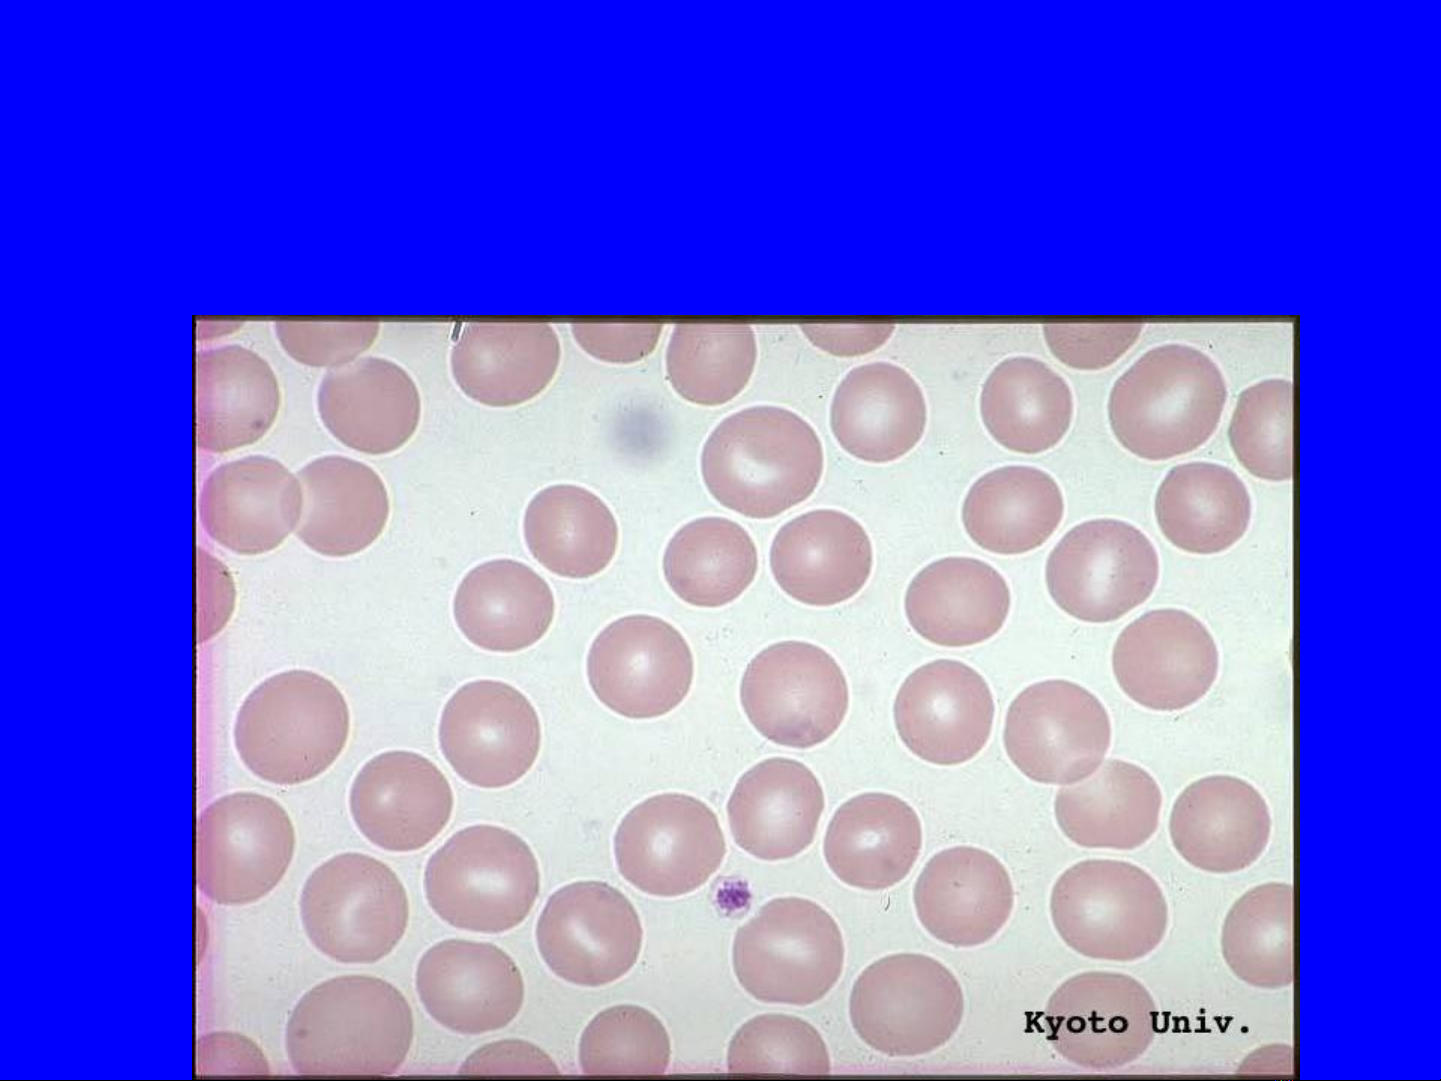

SINH LÝ BỆNH TẠO MÁU

•Trình bày được cách xếp loại thiếu
máutheo nguyên nhân, cơ chế bệnh
sinh
* Trình bày được sự thay đổi số lượng
bạch cầu ở máu ngọai vi
* Trình bày được đặc điểm và cáh
phân loại bệnh bạch cầu
MỤC TIÊU

•Quá trình biệt hoá của hồng cầu, bạch cầu và tiểu cầu

Rối loạn cấu tạo hồng cầu
1. Nhắc lại về tổ chức hồng cầu
-Nguồn gốc
-Chức năng và đời sống hồng cầu
Hướng dẫn sinh viên đọc tài liệu
HỒNG CẦU

